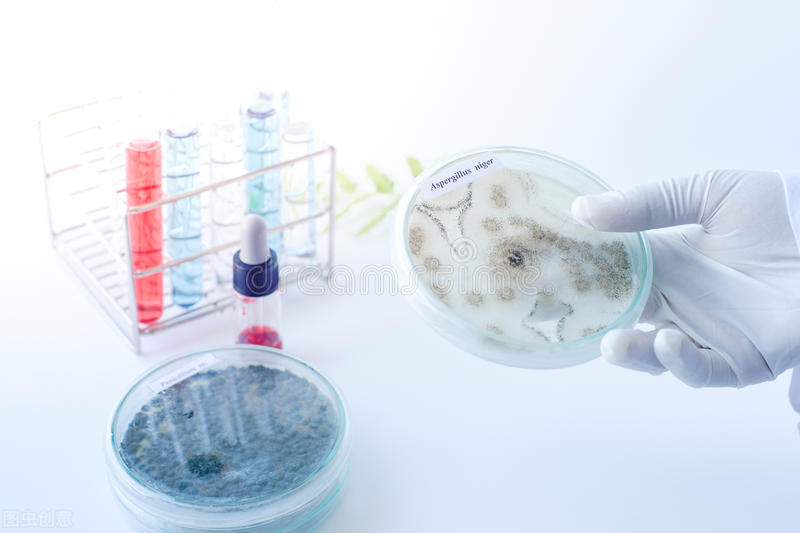
戴隐形眼镜刺痛流眼泪睁不开,戴隐形眼镜眼角流脓

半夜22点,被电话叫起:“医生医生,我刚刚眼角突然就开始分泌黄绿色黏黏的东西,然后视线就模糊了,看不清楚了,我赶紧把隐形眼镜取下来,发现下眼皮全是红得一直有黄白色的东西在分泌,就在眼睛里面,还很多,一条一条的,我弄出来过一会儿就又有了,我这是怎么了,怎么办啊?”

听完患者说症状及佩戴隐形眼镜的情况,立马就考虑感染了。
诊断“细菌性结膜炎”。
告诉他买抗菌眼药水及用法之后,第二天就好转了,嘱其维持用药及停药时间,这病才算告一段落。
戴隐形眼镜有哪些危害呢?
1.细菌感染;

临床试验中随机抽取佩戴隐形眼镜的人群,将佩戴一天的隐形眼镜放入培养基中进行细菌培养,其中结果令人震惊,其中培养出的细菌有:金黄色葡萄球菌、抗坏血酸克吕沃尔氏杆菌、沃氏葡萄球菌、表皮葡萄球菌、施氏葡萄球菌、人葡萄球菌和头状葡萄球菌。真菌有:曲霉菌;这些细菌就会引起我们的:
1)细菌性结膜炎:症状包括眼红、眼睑红肿、眼痒、眼烧灼感、流泪、晨起时分泌物多难以睁眼。
2)细菌性角膜炎:症状包括眼红、疼痛、畏光、流泪、视力降低、眼内刺痛、有异物感、眼睑痉挛及分泌物增多等。
3)巨乳头性结膜炎: 症状包括眼红、奇痒、流泪。检查可看见上睑结膜见硬而扁平的乳头如铺路石子样排列,伴有黏丝状分泌物。
2.真菌感染;
3%~28%健康人的结膜囊中也可分离出这些真菌,所以有角膜接触镜的擦伤,真菌就会感染我们的角膜就会引起:
1)真菌性角膜炎:起病缓慢,一天后才出现刺激症状而且较轻,伴视力障碍。这些真菌会分泌一些特异性的酶,会逐渐地侵蚀我们的角膜,造成角膜溃疡,穿孔,永久性视力下降甚至失明。
3.干眼症;
长期佩戴隐形眼镜会导致角膜缺氧,角膜就容易水肿,破皮,促使角膜表面产生新生血管,生成新生血管翳,永久影响我们的视力。
戴隐形眼镜的注意事项

1.一定要洗过手后再佩戴隐形眼镜。
2.勤换护理液,每天用每天换,不常用一周一换;注意瓶装护理液的有效期,不使用过期产品,尽量买好的。
3.每次佩戴时间不宜超过8小时,不要戴着隐形眼镜睡觉(非OK镜)。
4.免疫力低下时尽量不佩戴,例如感冒,例假,孕妇等。
5.有眼部疾病时禁止戴隐形眼镜。
6.有任何不适立即取出眼镜到医院就诊。
我致力于让全民大众都掌握基础医疗及救护知识。
关注我,学习更多医学知识,让平常生活不再不知所措。